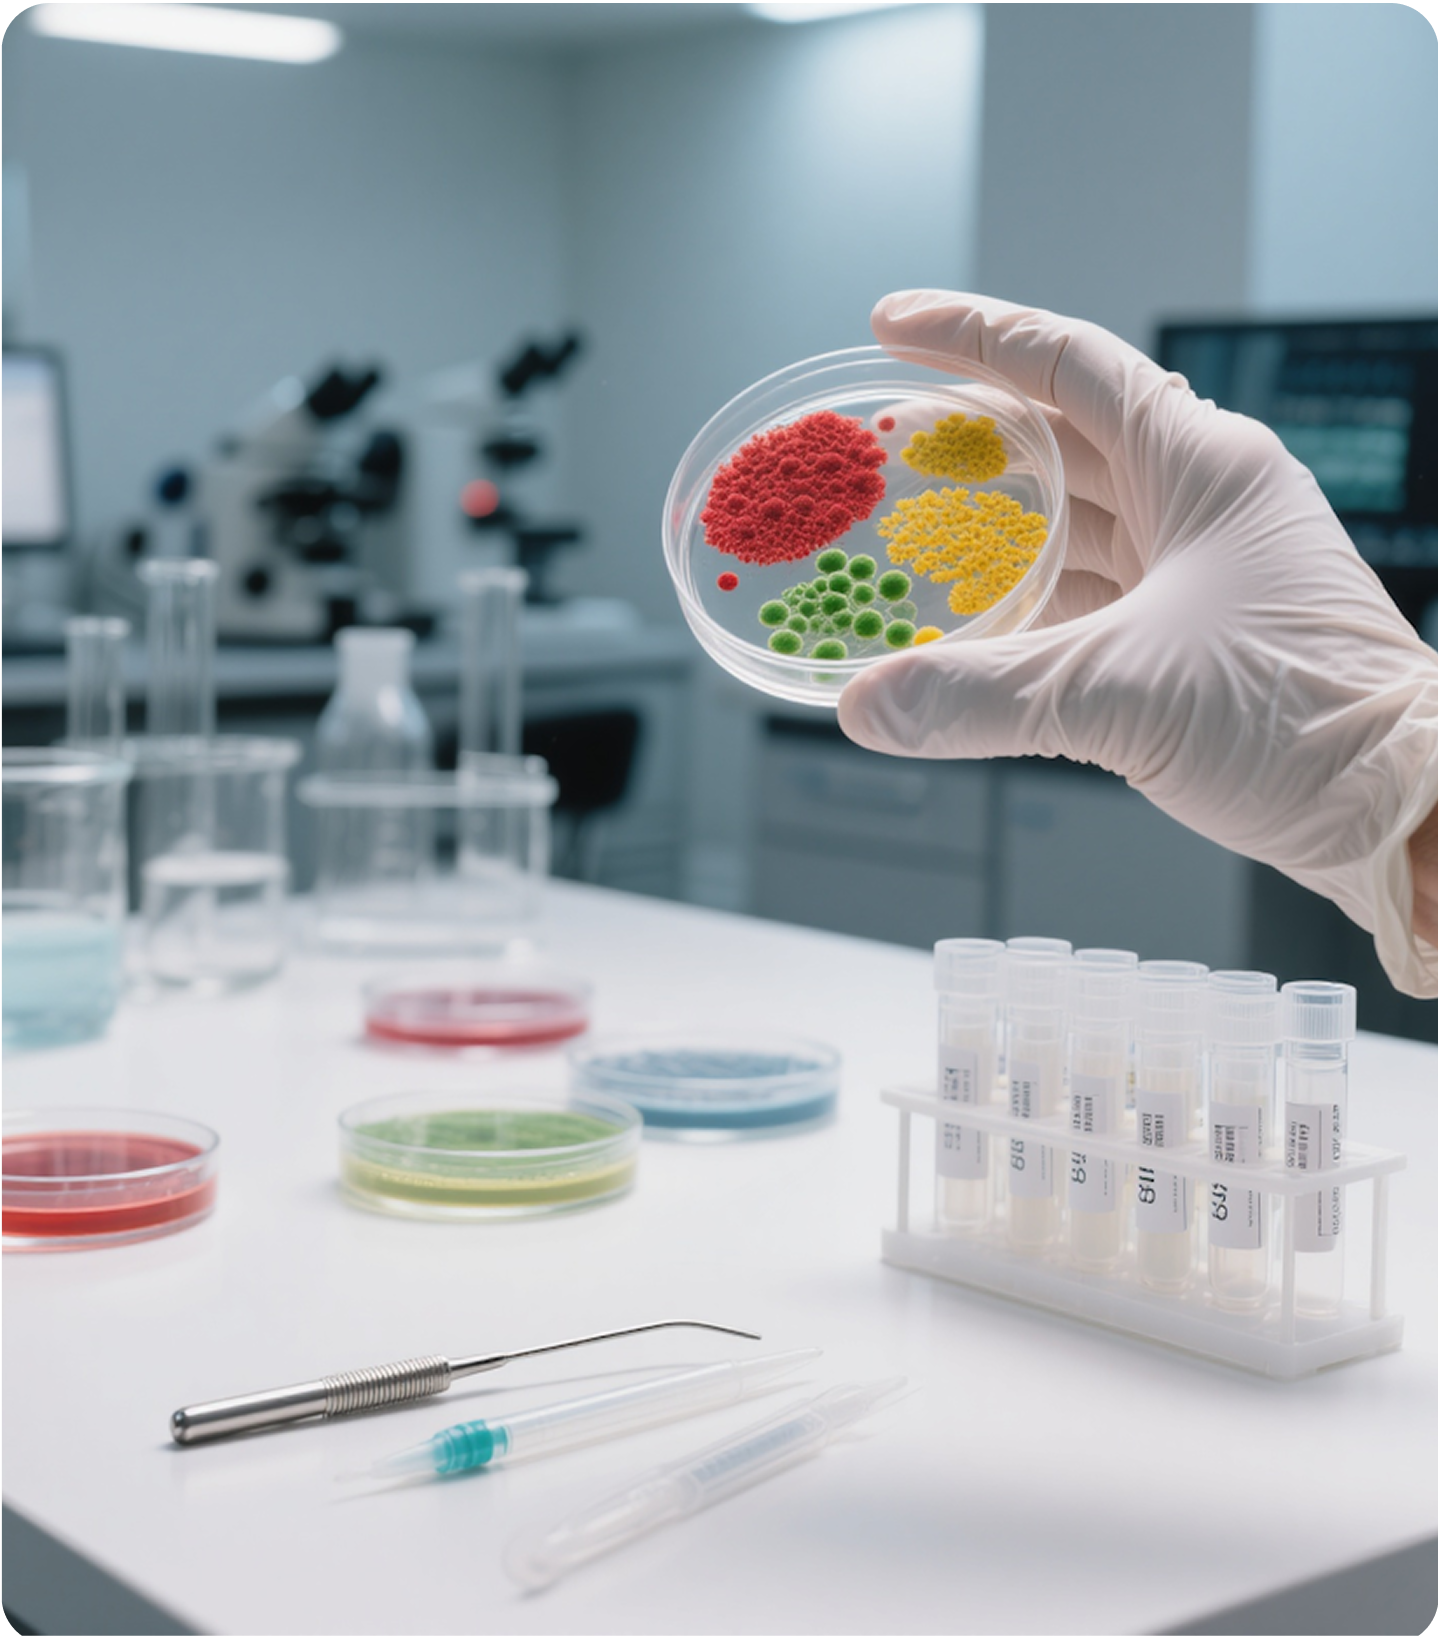

Our Case Studies
Explore the projects we’ve delivered across various industries

eTechSchool – Smart School Platform
R&D backed by data - FDA compliance - Improved Quality control
CLAIRITY TM - Pharma Tech
R&D backed by data - FDA compliance - Improved Quality control

Proof Checking-Artwork based smart checking
Auto-verify labels - Fast QA turnaround - Multi-language - Print-ready accuracy

Smart Vendy - Vending Automation for Retail
Simplified Buying - Broader Selection - Enhanced Customer Journey

Laws of Motion- Quiz and Image based AI/ML
Smart customer choice - Reduced waste - Simplified customer engagement

eTechschool bus and tracker connected commutes
Fleet management - Safe transport - Route optimization - Smart tracking

MHADA - eGovernance & Auto Document Validation
Lottery Digitization - Automated Checks - Cycle Time Reduction

ERP enabled smart governance for municipal bodies
Management Dashboards - Analytics - GIS Integration - Operational modules

SOLDIER FIGHT SEQUENCE – AR Combat Simulator
Battlefield Scenarios - AR-Powered Training

